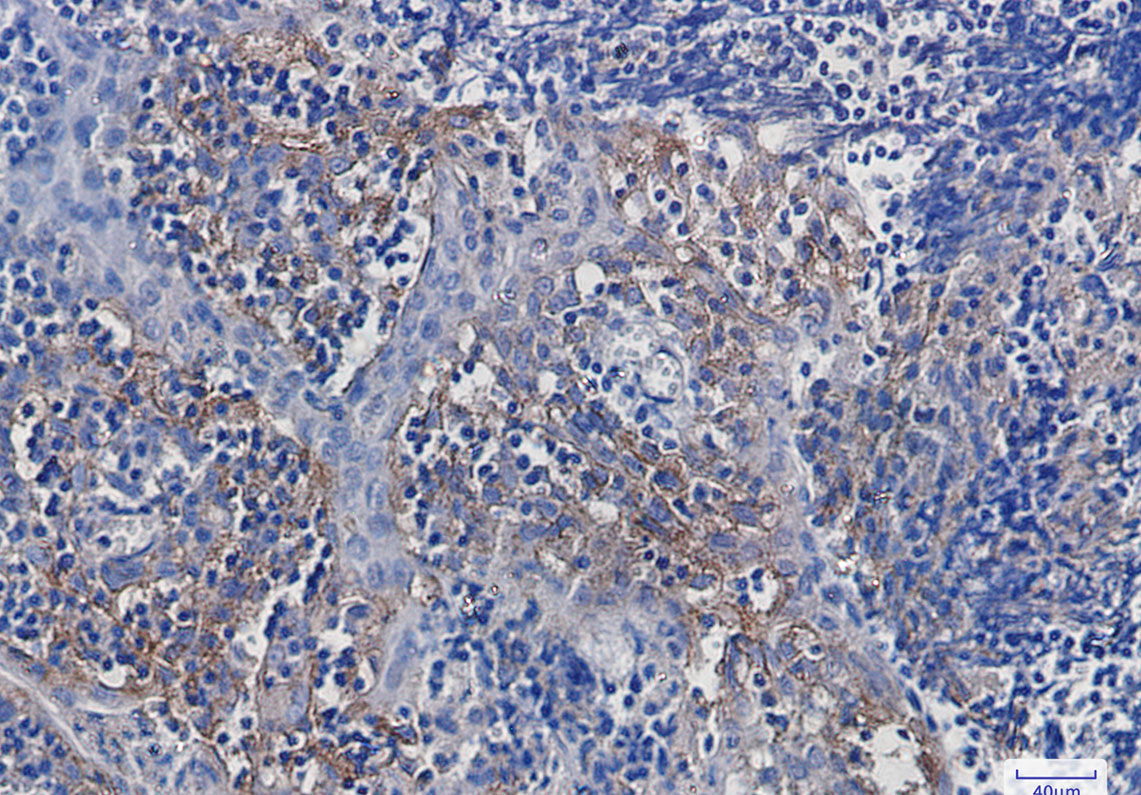

-
分类: 科研抗体货号: P20864别名: ITGAV; MSK8; VNRA; Integrin alpha-V; Vitronectin receptor subunit alpha; CD antigen CD51应用: WB,IHC反应种属: Human,Mouse,Rat
-
分类: 科研抗体货号: P20865别名: MEN1; SCG2; Menin应用: WB,IP反应种属: Human,Rat
-
分类: 科研抗体货号: P20863别名: PP4; PPX; PP4C; PPH3; PPP4应用: WB反应种属: Human,Mouse,Rat
-
分类: 科研抗体货号: P20880别名: Neurofascin应用: WB反应种属: Human,Mouse,Rat
-
分类: 科研抗体货号: P20888别名: Prolactin regulatory element-binding protein; Mammalian guanine nucleotide exchange factor mSec12应用: WB,IP,IHC反应种属: Human,Mouse,Rat
-
分类: 科研抗体货号: P20879别名: Pancreas-specific transcription factor 1a; bHLH transcription factor p48; PTF1-p48应用: WB,IP反应种属: Human,Rat
-
分类: 科研抗体货号: P20887别名: 6-phosphogluconate dehydrogenase; decarboxylating应用: WB,IP,IF反应种属: Human,Mouse,Rat
-
分类: 科研抗体货号: P20878别名: ANPEP; APN; CD13; PEPN; Aminopeptidase N; AP-N; hAPN; Alanyl aminopeptidase; Aminopeptidase M; AP-M; Microsomal aminopeptidase; Myeloid plasma membrane glycoprotein CD13; gp150; CD antigen CD13应用: WB,IP,IHC,IF反应种属: Human,Rat
-
分类: 科研抗体货号: P20886别名: Ras-related protein Rab-5C; RABL; L1880; RAB5L; RAB5CL应用: WB,IHC,IF反应种属: Human,Mouse,Rat
-
分类: 科研抗体货号: P20877别名: Cadherin family member 3; Desmocollin-4; HT-CP应用: WB,IF反应种属: Human

鄂公网安备42018502007531号
鄂公网安备42018502007531号

